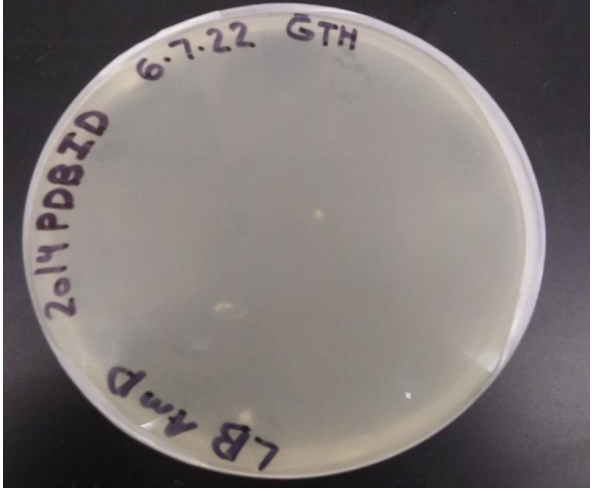

Image:Growthplate.png
From Proteopedia
(Difference between revisions)
No higher resolution available.
Growthplate.png (592 × 491 pixel, file size: 317 KB, MIME type: image/png)
Gregg T. Holliday (Talk | contribs)
(2O14 transformation plate growths. The transformation plate was made with LB medium, agar, and contained with 100 𝜇𝑔/𝑚𝐿 ampicillin.)
Next diff →
Current revision
2O14 transformation plate growths. The transformation plate was made with LB medium, agar, and contained with 100 𝜇𝑔/𝑚𝐿 ampicillin.
File history
Click on a date/time to view the file as it appeared at that time.
Date/Time | User | Dimensions | File size | Comment | |
---|---|---|---|---|---|
(current) | 16:51, 10 March 2024 | Gregg T. Holliday (Talk | contribs) | 592×491 | 317 KB | 2O14 transformation plate growths. The transformation plate was made with LB medium, agar, and contained with 100 𝜇𝑔/𝑚𝐿 ampicillin. |
- Edit this file using an external application
See the setup instructions for more information.
Links
The following pages link to this file: